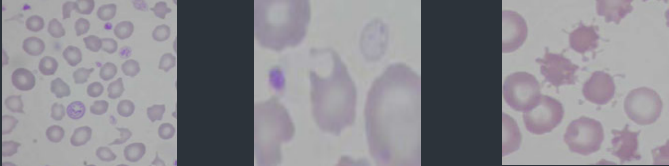
<p>Erythrocyte Fragmentation</p><p>What are these</p><p>Caused by?</p>
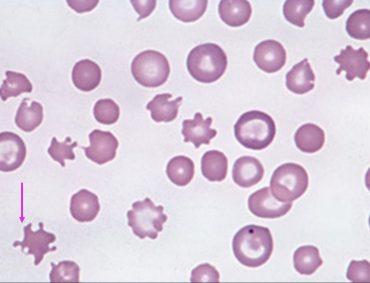

1/74
Looks like no tags are added yet.
Name | Mastery | Learn | Test | Matching | Spaced | Call with Kai |
|---|
No analytics yet
Send a link to your students to track their progress
Haemolytic anaemia – accelerated RBC destruction
DDX?
1. Immune mediated
2. Erythrocyte metabolic defect
a. Oxidative damage
b. Defect in ATP generation
3. Erythrocyte fragmentation
4. Infectious
5. Other (heparin, snake envenomation)
Immune Mediated Haemolytic anaemia
Causes inc?
1. Idiopathic (autoimmune)
Immune response directed at normal self epitopes
2. Drug induced
Develop abnormal antigens on erythrocyte cell membrane
3. Vaccine associated
4. Alloimmune
Neonatal isoerythrolysis
Blood transfusion reactions
IMHA - horses
Prevalence?
When it occurs it is usually secondary to?
Less common in horse c.f. dog
RBC parasites
Infection – Clostridial infection (20 -28%), Equine Infectious anaemia (EIA), Leptospirosis, Streptococcus equi.
Neoplasia – Lymphoma (13%), (melanoma)
Drugs – penicillin (13%), (trimethoprim- sulphamethoxazole)
IMHA - horses
Haemolysis location?
DX?
Extravascular more common
DX –multiple positives in a panel of tests (regenerative anaemia, persistent autoagglutination after washing, + Coomb’s test, spheroechinocytes, exclude other causes of regenerative anaemia)
IMHA - Neonatal Isoerythrolysis - Species?
Feline & Equine - Yes
Canine - 1 case
Bovine - Animals previously vaccinated (blood component)
Ovine - never
IMHA - Alloimmune mediated haemolytic anaemia
Caused by?
IMHA - Alloimmune mediated haemolytic anaemia (Neonatal Isoerythrolysis)
How does it work?
What is normally seen?
Important in who?
Immune mediated destruction (haemolysis or removal by
reticuloendothelial system) of foal/kitten RBCs caused by maternal antibodies ingested in colostrum
Born healthy → haemolytic anaemia → hallmarks pallor & icterus (0-8 days)
Horse and cats
IMHA - Alloimmune mediated haemolytic anaemia (Neonatal Isoerythrolysis) - Feline Neonatal Isoerythrolysis
How work?
Queen (type B) bred with Tom (type A) - kitten at risk if gets type A group
In colostrum type B blood with anti-A alloantibodies → kitten (type A or AB) ingests colostrum
Kitten has weak or no anti-B alloantibodies so can’t protect itself

IMHA - Alloimmune mediated haemolytic anaemia (Neonatal Isoerythrolysis) - Equine Neonatal Isoerythrolysis
How does it work? List the steps
1. Dam negative for RBC antigen (usually Aa or Qa)
2. Mare becomes sensitized & produce antibody to the offending antigen. (multiparous)
a. Previous blood transfusion
b. Previous pregnancy
c. Transplacental contamination with fetal RBCs earlier in current pregnancy (rare e.g. placentitis)
Certain RBC Ag factors are more antigenic: Aa & Qa
3. Foal inherits sire’s RBC antigen type
4. Foal ingests mare’s colostrum (concentrated with antibodies)
IMHA - Alloimmune mediated haemolytic anaemia (Neonatal Isoerythrolysis) - Equine Neonatal Isoerythrolysis
AB titer
Higher antibody titer at foaling – the higher the risk for NI
Highest titer – produced in a previously sensitized mare – that is reexposed to the same offending RBC antigen shortly before parturition

IMHA - Alloimmune mediated haemolytic anaemia (Neonatal Isoerythrolysis) - Equine Neonatal Isoerythrolysis
Clinical presentation?
Foal is normal at birth
Consumes colostrum concentrated with antibodies formed by mare including antibodies to sire’s RBCs (EAa or EQa)
If foal inherits sire’s RBC Ag type, within 24-48 hours foal is
- Anaemic (pallor)
- Icteric
- difficulty breathing
- reduced suckling
- requires intense medical treatment
- (can die acutely or present later)
MHA - Alloimmune mediated haemolytic anaemia (Neonatal Isoerythrolysis) - Equine Neonatal Isoerythrolysis
DX?
Anaemia: PCV 10-20% (5%)
Predominantly extravascular, but if intravascular component occurs then haemoglobinaemia & haemoglobinuria may be present
Hyperbilirubinaemia
(most unconjugated - due increased RBC destruction)
Total bilirubin (up to 20 mg/dl)

MHA - Alloimmune mediated haemolytic anaemia (Neonatal Isoerythrolysis) - Equine Neonatal Isoerythrolysis
Describe each photo
Icterus - Neonatal isoerythrolysis
Haemoglobinuria Pigmenturia
Haemoglobinuric nephropathy
MHA - Alloimmune mediated haemolytic anaemia (Neonatal Isoerythrolysis) - Equine Neonatal Isoerythrolysis - DX on a blood film what do we see
Anaemia (increased spaces/reduced density), agglutination
Anisocytosis – normal RBCs, macrocytes, Spherocytes
Metarubricytes & Howell Jolly bodies
Ghost cells

IMHA - Alloimmune mediated haemolytic anaemia (Neonatal Isoerythrolysis) - Equine Neonatal Isoerythrolysis
Diagnostic tests we use?
Definitive diagnosis requires demonstrating?
Alloantibodies in the dam's serum or colostrum that target foal erythrocytes
Haemolytic cross match test, Coombs test, Jaundiced foal test
IMHA - Alloimmune mediated haemolytic anaemia (Neonatal Isoerythrolysis) - Equine Neonatal Isoerythrolysis
Haemolytic cross match test?
washed foal RBC, mare serum & exogenous source of complement (usually rabbits) (positive at dilution>1:16)
IMHA - Alloimmune mediated haemolytic anaemia (Neonatal Isoerythrolysis) - Equine Neonatal Isoerythrolysis
Coombs test?
Often false negatives (because some equine alloantibodies act only as hemolysins, agglutination tests may be falsely negative)
IMHA - Alloimmune mediated haemolytic anaemia (Neonatal Isoerythrolysis) - Equine Neonatal Isoerythrolysis
– Jaundiced foal test.?
Serial dilutions of mare’s colostrum are centrifuged with foal’s RBCs. A positive reaction – identified by agglutinated (clump) RBCs bottom of a tube at dilution > 1:16

Neonatal Equine Alloimmune thrombocytopenia
How does it occur?
Maternal Ab pass through the colostrum and attach to foal platelets
Can be asymptomatic as condition may be self limiting due to rapid removal of alloantibodies
Neonatal Equine Alloimmune thrombocytopenia
CX if seen?
CBC?
Clinical- prolonged bleeding from venipuncture sites (petechial haemorrhage might not be seen)
Platelet count may be as low as 10 x 10 9/L
Neonatal Equine Alloimmune thrombocytopenia
Test?
Ab in colostrum or serum from mare against platelets
Neonatal Equine Alloimmune thrombocytopenia
DD’s for thrombocytopaenia
Sepsis
DIC
Drug induced
Angiopathies
Erythrocyte metabolic defect
Types and cause examples?
a. Oxidative damage
i. Heinz body haemolysis
ii. Eccentrocytic haemolysis
iii. Methaemoglobinaemia
b. Defects in ATP generation
i. Hypophosphataemic haemolysis
ii. PFK & PK deficiency
Erythrocyte metabolic defect - Oxidative damage
Occurs in?
Factors that determine the outcome of oxidative injury?
Dogs, cats, horses & ruminants
Not well understood (one substance can cause Heinz bodies in one species and methemoglobinaemia in another for example)
Erythrocyte metabolic defect - Oxidative damage
Anaemia occurs how?
e/v – RBC’s more rigid – less able to pass through splenic sinusoids – trapped & removed by macros
i/v – more fragile due to damaged membrane – may rupture spontaneously in blood vessels
antigen formation – when Heinz body binds RBC membrane, bound by autologous antibodies & removed the splenic or liver macrophages
Oxidative damage haemolysis - diagnosis
Anaemia – mild to severe
Polychromasia & reticulocytosis (regenerative)
Heinz bodies (NMB & Wrights or Diff quick) &/or Eccentrocytes (Wrights or Diff quick stain)
Haemoglobinaemia & haemoglobinuria (if intravascular haemolysis)
Hyperbilirubinaemia & Bilirubinuria
Severe cases – perhaps – Methaemoglobinaemia (dark or chocolate coloured blood)

What these?
how form?
Appearance in stains?
Heinz bodies
Aggregates of denatured Hgb caused by oxidative damage. may be free floating in blood stain sometimes
NMB stain as pale blue, protruding, rounded structures
associated with erythrocyte membranes
Wright-stained films, Heinz bodies have nearly the same staining features as normal Hgb but appear as slightly pale structures that create membrane defects or protrude
Heinz Body pathogenesis steps?
RBC has Oxyhaemoglobin (Fe2+) that carries oxygen normally → Oxidant overwhelms this mechanism → RBC has methaemoglobin (Fe3+) and can’t carry oxygen
Hgb-Fe3+ undergo spontaneous
conformational changes to form
hemichromes or heme-depleted Hgb
Hemichromes precipitate to
form Heinz bodies
During this Sulfhydral groups are
oxidized & form disulfide
bonds

Heinz body pathogenesis - cats
In health?
When are they pathogenic?
Cats – up to 5% Heinz bodies in health
“large” Heinz bodies or multiple Heinz bodies on RBC’s or > 5% RBC’s have Heinz bodies
Heinz body pathogenesis - cats
DX is?
regenerative anaemia, evidence haemolysis (bilirubinaemia, bilirubinuria), Heinz bodies, history of exposure
Heinz body pathogenesis – aetiological causes
Notable causes and which species involved?
Onion
All
Garlic
Dog
Horse (possibly)
Rums (ryegrass)
Benzocaine
Cat/dog
Horse (Maple leaf - dry) & alpaca
Rum (brassica spp - kale and rape)
Acetominophen (paracetamol)
Dog and cat
Napthalene (moth ball) - dog
Propylene glycol (wet cat food) - cat
Zn? - Dogs
Vitamin K1&3 - Dog
Propfol - Cat
Phenothiazine - Horse
Copper - Rums
Heinz body pathogenesis - cats
Cats and drug of note?
How does this work?
Acetaminophen (paracetamol) in cats bad, cat lack glucuronyl transferase which conjugates drug
No conjugation → acetaminophen becomes reactive metabolites → Glutathione conc depleted → Dec protection from oxidative injury
Heinz body pathogenesis - cats
Dz of note?
Diabetes mellitus
(> ketoacidotic)
Hyperthyroidism
Lymphoma
Zinc and IMHA?
Zinc can cause Heinz bodies & mimic IMHA
- Causes oxidative damage - forms Heinz bodies
- Band 3 clustering, opsonisation of antibody & spherocytes formation –
can lead to a miss diagnosis of IMHA

What this?
DX how?
Features?
Sheep with heinz bodies = chronic copper toxicity
Diagnosis: elevated serum, liver & kidney copper
•Preceded by chronic copper accumulation in hepatocytes
•Sudden release of Cu, often after stress, acute intravascular haemolysis, haemoglobinaemia, haemoglobinuria – death in 2-3 days

What is this?
Describe it
Eccentrocyte aka Bite cell or hemighost
the haemoglobin is pushed to one side of the cell leaving an opposing pale stain
Eccentrocyte pathogenesis
Oxidation → erythrocyte membranes bond → collapsed, peripheral, crescent - shaped region of the cell (sometimes called a blister cell) and the cell’s Hgb is displaced eccentrically
Eccentrocyte pathogenesis - Causes inc?
Causes are similar to some things that cause Heinz bodies
(dogs, horses & cattle)
Exogenous oxidants: onions, garlic, acetaminophen, propylene glycol, zinc.
Endogenous oxidants: in very sick patients e.g. diabetes mellitus
Methaemoglobinaemia
Causes inc?
Drugs/toxins
-Paracetamol (cats, dogs)
Plants
-Onions
-Red Maple Leaf (horses)
-Nitrite (nitrate in plant/fertilizer)

Methaemoglobinaemia pathogenesis - steps?
Oxidant overwhelms RBC mechanisms to keep Hgb in reduced state
RBC with oxyhaemoglobin (Fe2+) that carries oxygen becomes Methaemogobin (Fe3+) which can’t carry oxygen

Methaemoglobinaemia pathogenesis
Effects of Methaemoglobinaemia?
How much is normal amounts of methaemoglobin in the blood?
Initially cyanotic (cannot deliver O2)
Later as Fe3+ > 10% mucous membranes appear brown
Normally about 1 to 3% of blood is in methaemoglobin state

Methaemoglobinaemia pathogenesis
Reductive pathways to protect RBC from oxidative damage include?
1. Reduced by NADH dependent methaemoglobin reduction pathway
2. Glutathione reductase pathway

Erythrocyte metabolic defect
b. Defects in ATP generation inc?
i. Hypophosphataemic haemolysis
ii. PFK & PK deficiency
Defects in ATP generation - Hypophosphataemic haemolysis - pathogenesis
Severe hypophosphataemia can be life
threatening, y?
Severe hypophosphatemia may lead to reduced RBC ATP production (energy) (& decreased glutathione) → unstable RBC membrane → haemolysis
Depressed myocardial function, rhabdomyopathy, seizure, coma, acute respiratory failure
Defects in ATP generation - Hypophosphataemic haemolysis
Causes inc?
1. Post Parturient Haemoglobinuria – cattle (most common)
2. Hyperinsulinism associated with hyperglycaemia (domestic animals)
3. Sporadic hypophosphatemia (horses, dogs & cats)
4. Artefact – bilirubin interference
Defects in ATP generation - Hypophosphataemic haemolysis - Post Parturient Haemoglobinuria – cattle
Pathophysiology
DX?
What can complicate it?
3 - 8 weeks post calving (sporadic multiparous cow)
Defective phosphorus mobilization from bone
Increased phosphorus loss via milk
Laboratory diagnosis
Anaemia – moderate to marked intravascular haemolysis (haemoglobinaemia & haemoglobinuria)
Hypophosphataemia
There is decreased ATP and Glutathione
Complicated with concurrent ketosis. Ketones potentially generate in vivo oxygen radicals – that can lead to formation of Heinz bodies
Defects in ATP generation - Hyperinsulinism hypophosphataemia haemolysis
Pathogenesis?
Hyperinsulinism – promotes movement of phosphate and glucose into cells other than RBC’s
(Insulin not needed for glucose to enter RBC’s)
Defects in ATP generation - Hyperinsulinism hypophosphataemia haemolysis
Cat signalment?
Pathogenesis?
Diabetic cats polyuria may lead to hypophosphataemia - hence haemolysis
Complicated like post parturient cattle they may have concurrent ketosis
Therefore combination of Hypophosphataemic & ketotic (Heinz body) haemolytic anaemia
Hypophosphataemia – artefact Bilirubin interference
Analyser & method dependent
Therefore be careful of interpreting the concurrent presence of hypophosphataemia and haemolytic anaemia in the presence of hyperbilirubinaemia
Regenerative anaemia – RBC fragmentation
Erythrocyte Fragmentation causes inc
1. Intravascular coagulation (localised or disseminated)
2. Vasculitis
3. Haemangiosarcoma
4. Rheological process - Cardiac valvular disease
Erythrocyte Fragmentation
What are these
Caused by?
Left - Schizocytes
Middle - keratocytes
Right - Acanthocytes
Form when blood forced to flow through an altered vascular channel or turbulent blood flow.

Erythrocyte Fragmentation
Erythrocyte fragmentation in blood due to physical injury
Features and the ass. dz?
Fibrin – traumatic injury to RBC membrane
Intravascular coagulation (localised or DIC)
Vasculitis
Rheological forces (blood flow)
Cardiac valvular Dz
Caval syndrome or dirofiliariasis
“Membrane lipid changes” but cells are more fragile due to the forces - Haemangiosarcoma
Schistocyte or schizocyte
Which is correct for fragments, why?
Pathogenesis?
Schizo = cut
“any shaped” irregular small piece of RBC
Same conditions as keratocytes
DIC
Haemangiosarcoma
Endocarditis
Caval syndrome


What this?
Describe appearance
Keratocyte – Helmet or blister cell
RBCs with one or more ruptured/intact clear vesicles
Ruptured ones make cell looks like it has 2 projections
They are areas of apposed & sealed membrane rather than a true vesicle
Keratocytes - pathogenesis
Low numbers of keratocytes?
Chemicals?
When is it significant?
Low numbers seen in many situations but may not have significance e.g. healthy cats
Collection in EDTA may increase their presence. Make a blood smear immediately
When present in larger numbers or with other poikilocytes
Keratocytes - pathogenesis
When present in larger numbers or with other poikilocytes, keratocytes can indicate the following…
Fragmentation injury
Oxidant injury
Liver disease
Keratocytes - pathogenesis
When present in larger numbers or with other poikilocytes, keratocytes can indicate Fragmentation injury
Describe
Microangiopathic hemolysis (DIC, vasculitis, hemangiosarcoma) (fibrin) mechanical fragility, e.g. iron deficiency anemia. (schistocytes & acanthocytes)
Keratocytes - pathogenesis
When present in larger numbers or with other poikilocytes, keratocytes can indicate oxidant injury
Describe
Keratocytes may accompany eccentrocytes, & possible Heinz bodies, depending on the oxidant
Keratocytes - pathogenesis
When present in larger numbers or with other poikilocytes, keratocytes can indicate Liver disease
Describe
In cats, inc keratocytes in liver dz e.g. hepatic lipidosis
Not sure why, may be due to mechanical fragility from altered phospholipid or cholesterol composition of the RBC membrane (membrane rigidity) or DIC
What this?
Sig in dogs?
Goats?
Acanthocyte
Dogs - Diseases with increased fragmentation e.g.
• Haemangiosarcoma
• Liver disease
• DIC
• glomerulonephritis
Young goats: normal as have haemoglobin C when young

Acanthocyte - pathogenesis
Dogs?
Mechanism is currently unknown. They might be present due to fragmentation (DIC, Fe deficiency)
Acanthocytes – clue for haemangiosarcoma (dogs)
Acanthocytes could be considered as a “blood biomarker” for haemangiosarcoma
Their presence in significant numbers should prompt?
Lab Aspects?
Basic workup including abdo(splenic or hepatic tumor) & cardiac (atrial tumor) US
Strongly regenerative anaemia if the spleen ruptures
Sometimes NRBC’s
Frequently accompanied by schistocytes & thrombocytopaenia suggesting fragmentation injury. (DIC)
Dogs and liver disease features acanthocytes, what else?
Presence of anaemia is variable, non or regenerative
depending on primary cause (hepatitis, infiltrative neoplasia (lymphoma), liver failure.
Regenerative anaemia - Infectious
Infectious agents associated with erythrocytes inc?
Anaplasma marginale
Anaplasma centrale
Babesia spp.
Distemper
Mycoplasma spp.
Mycoplasma haemocanis
Mycoplasma haemofelis
Candidatus Mycoplasma haemominutum
Theileria spp.

Regenerative anaemia - Infectious
Presence/Absence of organism?
Degree of clinical dz?
Many of the infectious agents have?
Don’t confuse what with agents?
Presence of an organism is diagnostic but its absence does not rule out the infection.
The degree of parasitaemia does not necessarily correlate with the degree of clinical disease
A concurrent immune mediated component (check for
spherocytes & agglutination)
Refractile artefact or stain precipitate

Regenerative anaemia - Infectious
Blood smear aspects?
Send fresh blood smears made at the time of collection of the EDTA, as epicellular organisms may dislodge from the erythrocyte membrane.
Capillary blood smears (prick ear) may be more helpful than normal jugular or cephalic vein.
Buffy coat smears may help concentrate some infectious agents
Infectious agents associated with erythrocytes
Mycoplasma aspects?
Thus, if confirmation of the parasite is sought from an outside consultant, what do?
Next steps in this case?
Mycoplasma are on outside of RBCs → blood smears should be made soon after collection lest they dislodge from membrane
If dislodged they are free in extracellular space and look a lot like stain precipitate
Premade blood smears should be submitted along with an EDTA tube of whole blood
NEXT STEPS
Look for underlying disease (FeLV, neoplasia, spleen, immunocompromised)
Follow up with PCR
Check blood smear for agglutination as often a concurrent immunemediated component to the anaemia.
Other causes of haemolytic anaemia?
1. Heparin induced haemolysis
2. Envenomation (snakes)
Dots – not to be confused
Look around – look for the company they keep to help you distinguish
Describe this?
Howell – jolly bodies & basophilic stippling may be increased with a regenerative anaemia (polychromatophils)
Distemper usually has leukopaenia & lymphopaenia & inclusions can be present in RBCs & WBCs.

Dots - Which is what?

Heparin induced haemolysis
In who? How?
Pathogenesis?
Some horses - heparin anticoagulant therapy → RBC agglutination
6-8 hrs after TX
Resolves after 5 days
Anaemia pathogenesis unclear - potentially RBC destruction in agglutinated groups in vivo
Hyperbilirubinaemia (due to inc RBC destruction)
Envenomation Venom from some snakes, spiders & insects may cause haemolysis
Mechanisms/pathogenesis include?
Activate complement (cobra venom factor)
Haemolysins causing direct haemolysis (e.g. phospholipase A2 in rattlesnake venom)
Bee stings
– haemolysins (phospholipase A2)
– spherocytic haemolytic anaemia
(altered membrane structure or antibody mediated)